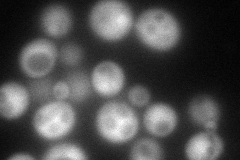
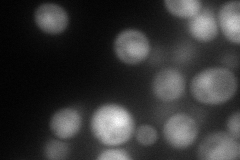
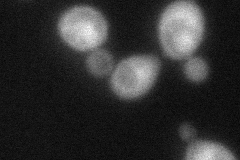
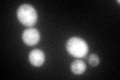
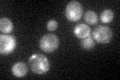

View description
Essential protein with two zinc fingers, present in the nucleus of growing cells but relocates to the cytoplasm in starved cells via a process mediated by Cpr1p; binds to translation elongation factor eEF-1 (Tef1p)
Localization:
Intensity:
Fold change:
Significance:
-
C’ GFP library in SD

nucleus:cytosol137.47 -
N' NOP1pr-GFP in SD
cytosol145.943 -
N' TEF2pr-mCherry in SD
nucleus117.171 -
N' NATIVEpr-GFP in SD

cytosol85.2333 -
N' TEF2pr-VC and Cyto-VN in SD
cytosol,nucleus59.9879 -
C’ GFP library in SD+DTT
nucleus.cytosol91.450.66No -
C’ GFP library in SD+H2O2

nucleus.cytosol126.010.91No -
C’ GFP library in Starvation Media
nucleus,cytosol68.290.49Yes -
C’ GFP library on the background of Pup2-DaMP

nucleus:cytosol -
C’ GFP library on the background of CCT mutant

nucleus:cytosol132.7380.965492No
